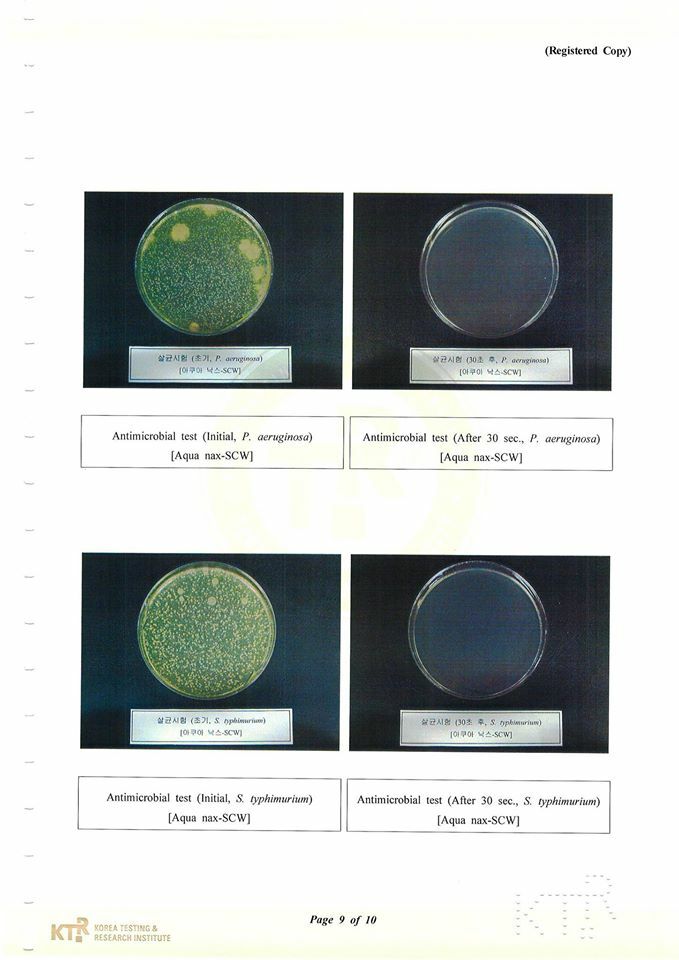

{{ 'product.bundled_products.label' | translate }}
{{ 'product.bundle_group_products.label' | translate }}
{{ 'product.buyandget.label' | translate }}
{{ 'product.gift.label' | translate }}
{{ 'product.addon_products.label' | translate }}
{{item.product.title_translations|translateModel}}
{{ field.name_translations | translateModel }}
{{ 'product.set.open_variation' | translate }}
-
{{ getSelectedItemDetail(selectedChildProduct, item).childProductName }}
x {{ selectedChildProduct.quantity || 1 }}
{{ getSelectedItemDetail(selectedChildProduct, item).childVariationName }}
{{item.variation.name}}
{{item.quantity}}x
HK$0
{{ item.unit_point }} 點